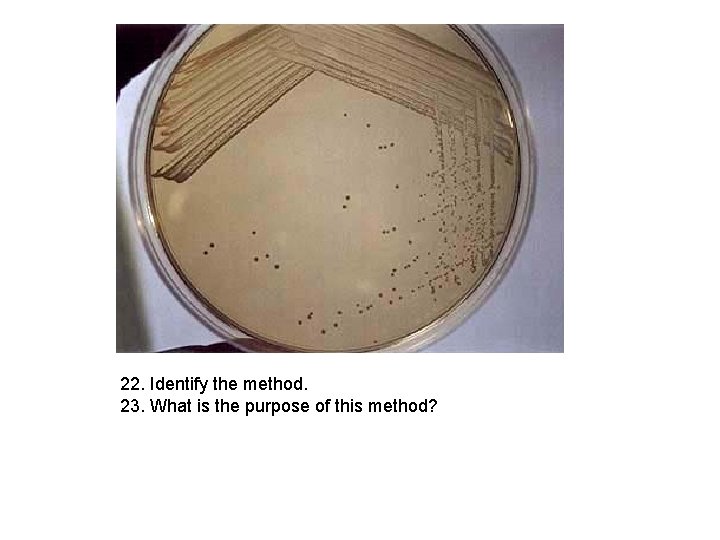
22. Identify the method. 23. What is the purpose of this method?
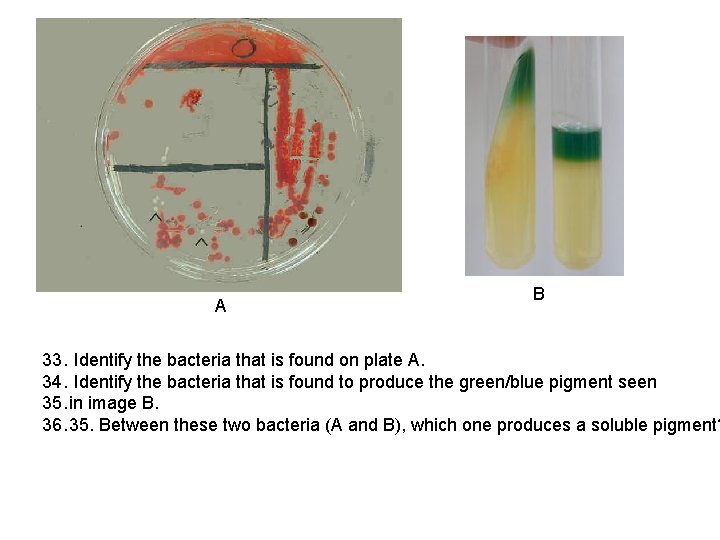
A B 33. Identify the bacteria that is found on plate A. 34. Identify
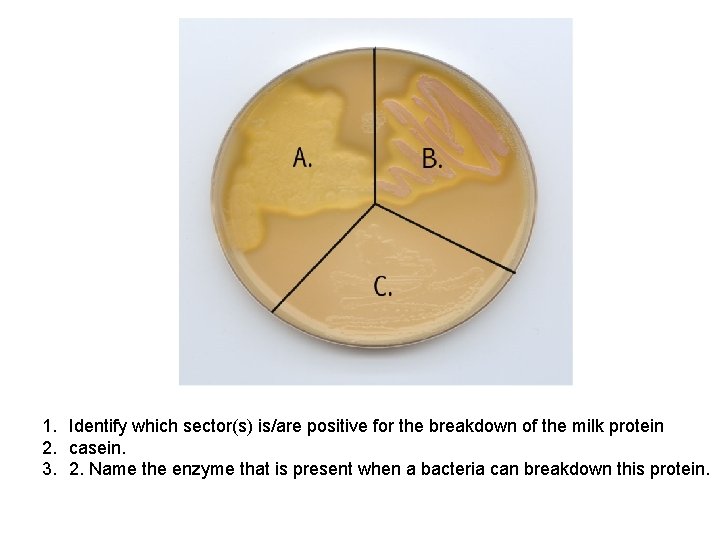
1. Identify which sector(s) is/are positive for the breakdown of the milk protein 2.
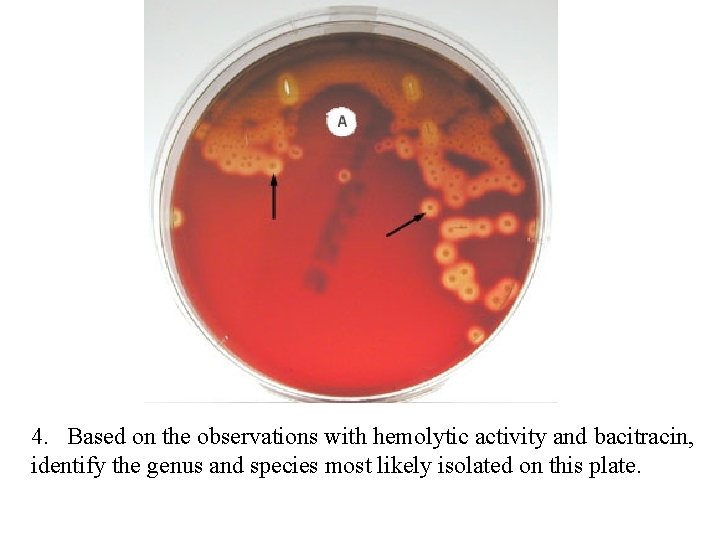
4. Based on the observations with hemolytic activity and bacitracin, identify the genus and
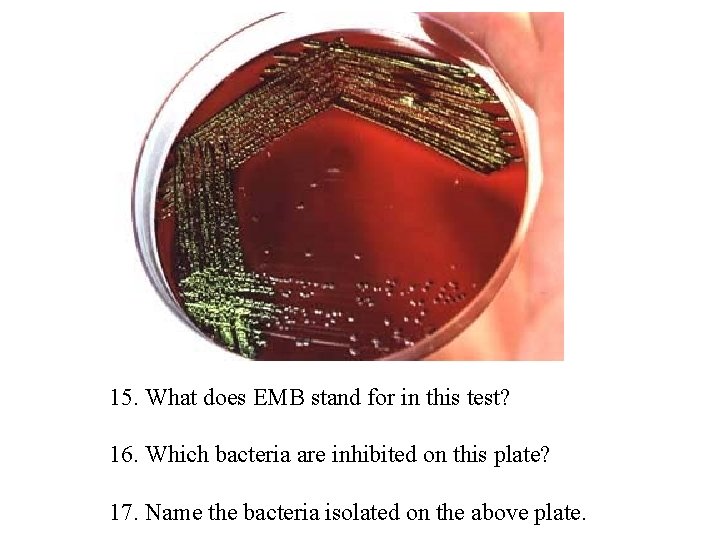
15. What does EMB stand for in this test? 16. Which bacteria are inhibited
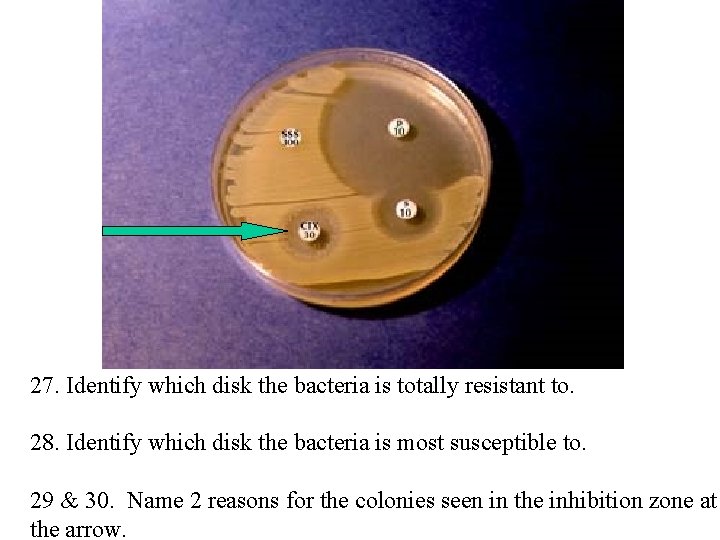
27. Identify which disk the bacteria is totally resistant to. 28. Identify which disk
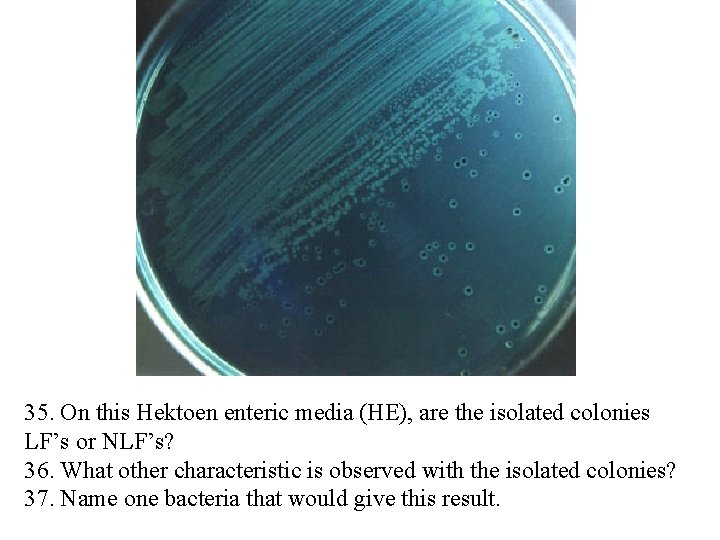
35. On this Hektoen enteric media (HE), are the isolated colonies LF’s or NLF’s?

BIO 2420 Intro to Microbiology Sample Comprehensive Laboratory

BIO 2420 Intro to Microbiology Sample Comprehensive Laboratory exam Created by R. Rohde www. austincc. edu/rohde

5. Identify the gram reaction seen at the pointer. 6. Identify the morphology (shape). 7. Identify the arrangement.

11. Identify the staining technique. 12. What is the purpose of the white structure seen at the pointer. 13. Why is an acidic dye used for this technique?

14. 15. 16. 17. Identify the staining technique. Identify the purpose of iodine in this technique. Name the primary morphology seen in the slide. Name the most likely Genus and species seen in this image.
22. Identify the method. 23. What is the purpose of this method?

A B C 36. Identify which tube illustrated a non-motile organism.

37. Identify microscope part # 1 38. What is the magnification of part #1? 39. Identify microscope part # 6 that is labeled 10 X. 40. What is the magnification when 41. using the oil immersion objective lens
A B 33. Identify the bacteria that is found on plate A. 34. Identify the bacteria that is found to produce the green/blue pigment seen 35. in image B. 36. 35. Between these two bacteria (A and B), which one produces a soluble pigment?
1. Identify which sector(s) is/are positive for the breakdown of the milk protein 2. casein. 3. 2. Name the enzyme that is present when a bacteria can breakdown this protein.

14. In the nitrate reduction test shown above, what two reagents were added to determine if nitrate reductase is present? 15. 2 nd reagent 16. What 3 rd reagent must be added to the inconclusive tube above to determine if nitrate 17. has been totally reduced? 17. If the inconclusive tube stays the same color as above after this reagent (#16 answer) 18. is added, what does that outcome mean?

18. Identify the end-product that has been produced in the tube on the right. 19. Identify the amino acid that is the substrate in this test. 20. For which bacteria, is this test a presumptive test (positive indicator)?

26. Name the test. 27. Name the p. H indicator in this test. 28. What is the purpose of this test?

50. You have been given a sample of urine to determine whether or not 51. it’s likely to be a urinary tract infection (UTI). The only information you know 52. is that you have a gram negative rod in the urine that “swarms” on agar. The 53. only biochem test you have available in the lab is the urea test and it turns up positive 54. Based on this information, what is the most likely organism that is causing this UTI?
4. Based on the observations with hemolytic activity and bacitracin, identify the genus and species most likely isolated on this plate.

45. Which family of bacteria is the IMVi. C test useful for most often? 46. The following results were noted for the IMVi. C test (+, +, -, -). Based 47. on these results, what is the identification of the most likely gram-negative 48. enteric that we’ve studied in our lab? 49. 47 and 48. If the IMVi. C results were reversed (-, -, +, +), which two likely gram 50. negative enterics would you suspect based on our labs? 51. 49. Which simple test could one use to differentiate between these two bacteria?

7. The culture turned purple within 15 seconds of adding the oxidase reagent to the swab. Is this a positive or negative test? 8. Name which bacteria is positive for this test that also is assachrolytic and produces a bluishgreen pigment.

9. Identify this selective and differential media that allows for Differentiation between Staph. aureus and Staph. epidermidis. 10. Name which sector you would find S. aureus. 11. Name the ingredient that makes this plate “selective”. 12. Why is sector “ 1” turning yellow?
15. What does EMB stand for in this test? 16. Which bacteria are inhibited on this plate? 17. Name the bacteria isolated on the above plate.
27. Identify which disk the bacteria is totally resistant to. 28. Identify which disk the bacteria is most susceptible to. 29 & 30. Name 2 reasons for the colonies seen in the inhibition zone at the arrow.

An enteric culture gave the following results: gram positive cocci, Gamma/alpha hemolytic, bacitracin negative, optochin negative, Bile esculin slant tube entirely black, 6. 5% Na. Cl broth turbid. 41. Based on the results above, name the genus and species of the most likely bacteria. 42. Name the beta-hemolytic, gram positive bacteria that is found in the Group B streptococcus organisms. 45. A skin swab gave the following results: gram positive cocci, Catalase positive, halophile, ferments mannitol. Based on these results, name the most likely genus and species.
35. On this Hektoen enteric media (HE), are the isolated colonies LF’s or NLF’s? 36. What other characteristic is observed with the isolated colonies? 37. Name one bacteria that would give this result.

8. Identify by genus and species.

cyst trophozoite 12. Identify this protozoan that can cause dysentery from drinking non-purified water when camping, etc. 13. What class does this protozoan belong to?

26. Identify this flagellate protozoan (genus only). 27. Name the type of specimen (urine, etc. ) one would have to acquire to view this microbe.

4. Identify the helminth (Genus & species that produces this egg. ) It is the #1 roundworm infection in the USA. 5. Specifically, how would one obtain a sample of these eggs to ID them for a clinical diagnosis?

6. Identify this microbe by genus. 7. Name the class?
- Slides: 26